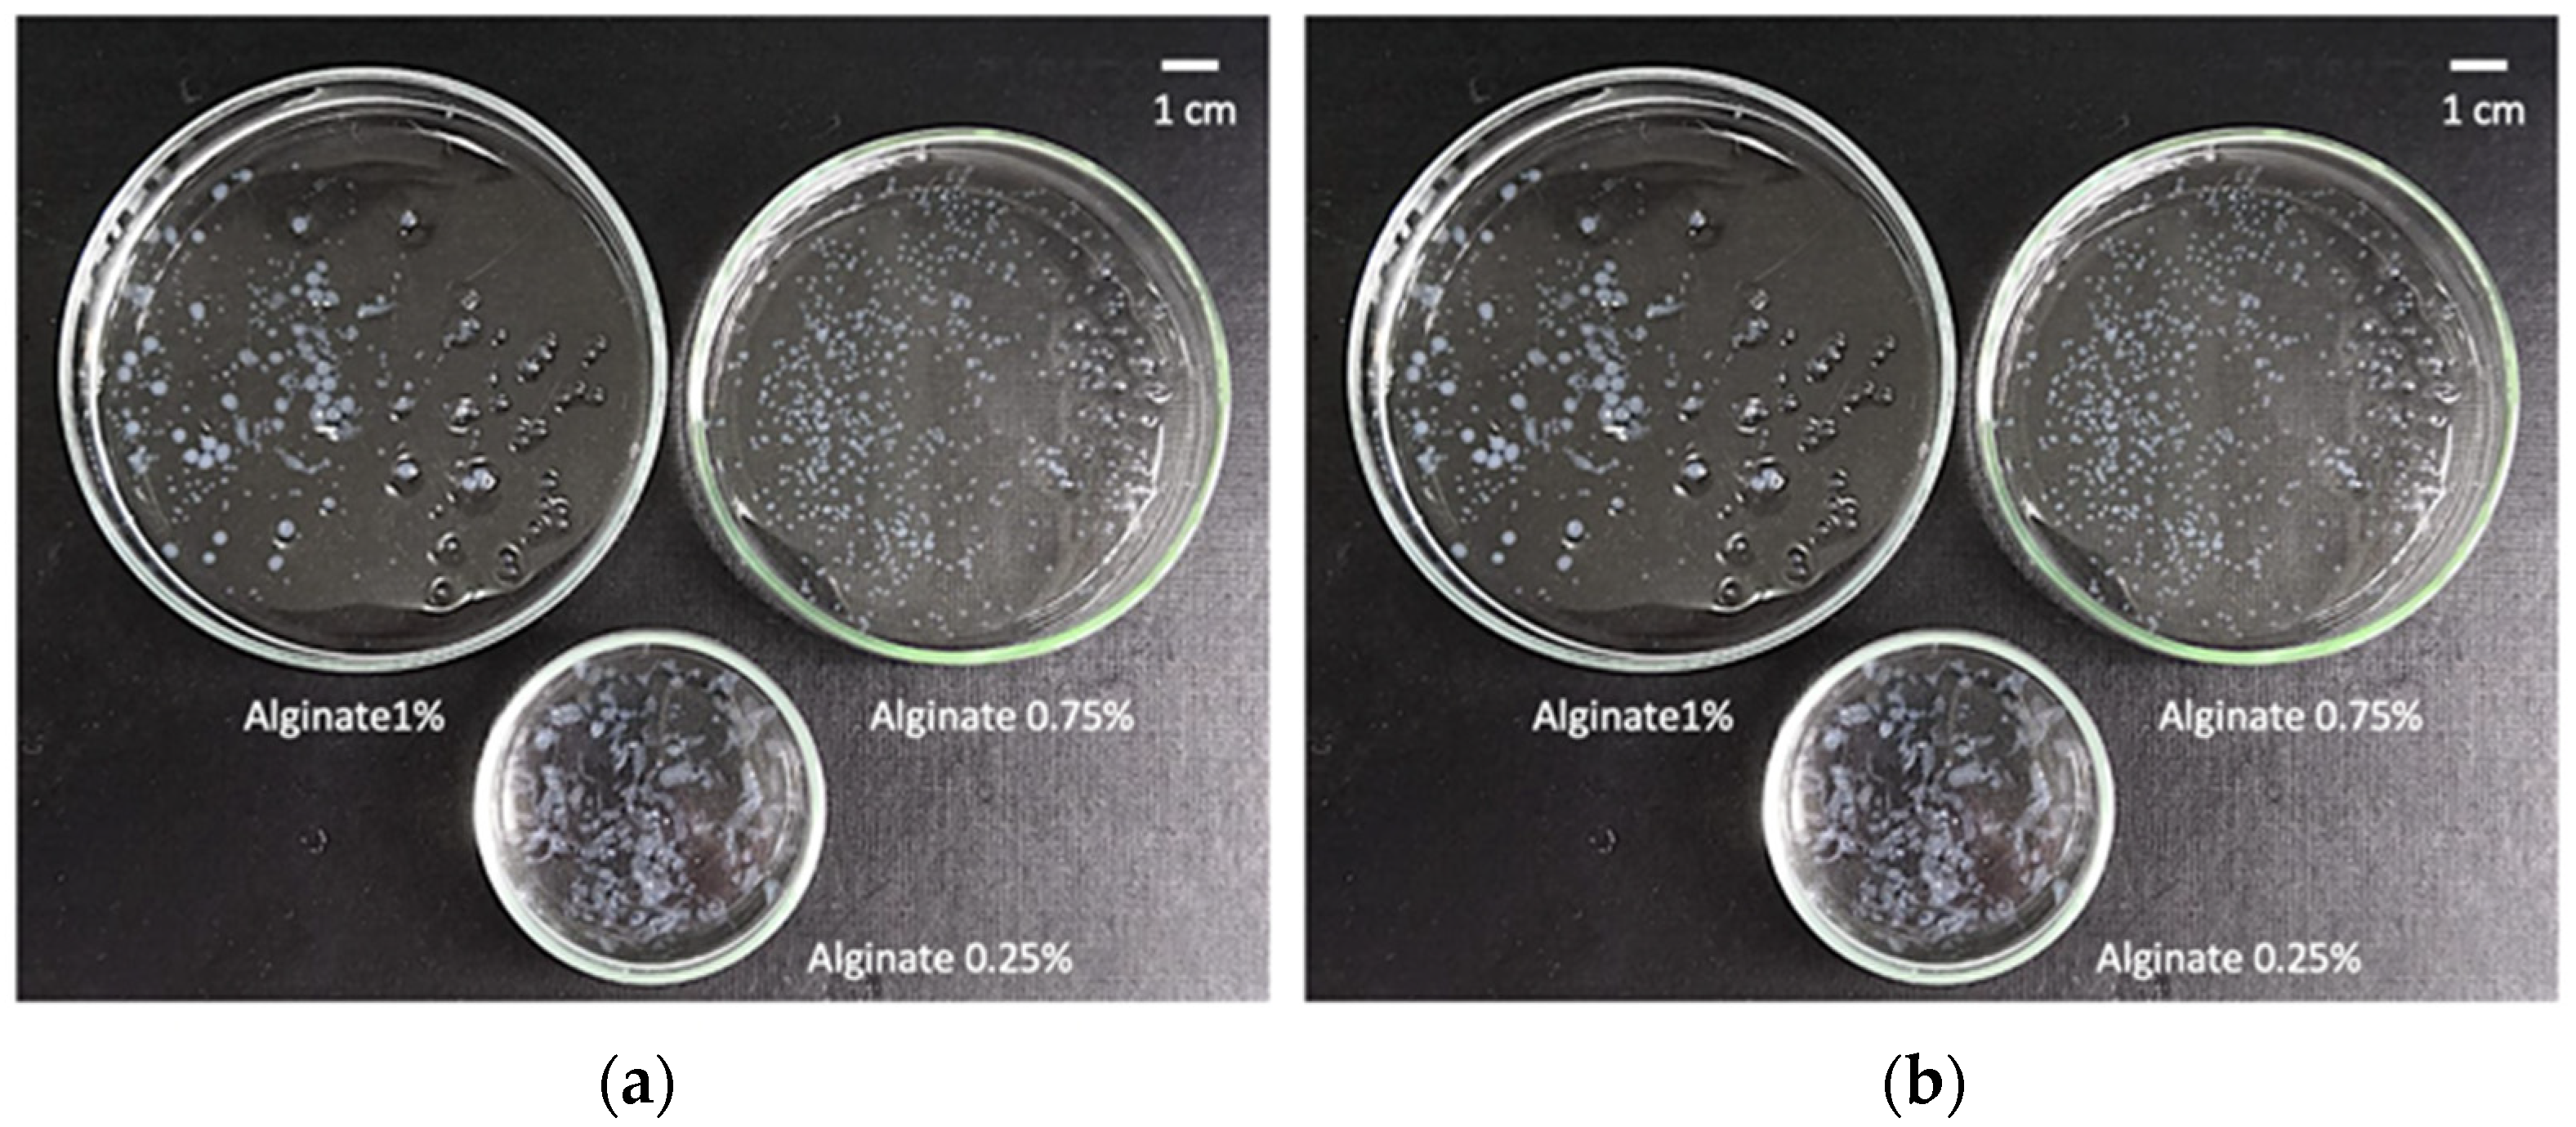
Gels 08 00417 g001

Preparation of Vancomycin-Loaded Aerogels Implementing Inkjet Printing and Superhydrophobic Surfaces
Abstract
:1. Introduction
2. Results and Discussion
2.1. Definition of Operating Window for Alginate Aerogel Preparation
2.2. Production of Vancomycin-Loaded Aerogels Using Superhydrophobic Surfaces
2.3. Morphological and Physicochemical Characterisation of Alginate Gels and Aerogels
2.4. Vancomycin Release Studies from Alginate Aerogels
3. Conclusions
4. Materials and methods
4.1. Materials
4.2. Preparation of Superhydrophobic Surfaces
4.3. Preparation of Alginate Aerogel Microspheres
4.3.1. Determination of Optimal Concentration of The Alginate and CaCl2 Solutions
4.3.2. Preparation of Alginate Hydrogels by Gel Inkjet Printing Using Superhydrophobic Surfaces
4.3.3. Solvent Exchange and Supercritical Drying of Alginate Gels
4.4. Alginate Gels Characterization
4.4.1. Morphological and Physicochemical Properties of Alginate Beads
4.4.2. Vancomycin Drug Content and Loading Efficiency
4.4.3. Vancomycin Release from Alginate Aerogels
Supplementary Materials
Author Contributions
Funding
Data Availability Statement
Acknowledgments
Conflicts of Interest
References
- Wang, P.H.; Huang, B.S.; Horng, H.C.; Yeh, C.C.; Chen, Y.J. Wound healing. J. Chin. Med. Assoc. 2018, 81, 94–101. [Google Scholar] [CrossRef] [PubMed]
- Han, G.; Ceilley, R. Chronic wound healing: A review of current management and treatments. Adv. Ther. 2017, 34, 599–610. [Google Scholar] [CrossRef] [PubMed] [Green Version]
- Las Heras, K.; Igartua, M.; Santos-Vizcaino, E.; Hernandez, R.M. Chronic wounds: Current status, available strategies and emerging therapeutic solutions. J. Control. Release 2020, 328, 532–550. [Google Scholar] [CrossRef] [PubMed]
- Sen, C.K. Human wound and its burden: Updated 2020 compendium of estimates. Adv. Wound Care 2021, 10, 281–292. [Google Scholar] [CrossRef]
- Negut, I.; Dorcioman, G.; Grumezescu, V. Scaffolds for wound healing applications. Polymers 2020, 12, 2010. [Google Scholar] [CrossRef]
- Esquivel-Castro, T.A.; Ibarra-Alonso, M.C.; Oliva, J.; Martínez-Luévanos, A. Porous aerogel and core/shell nanoparticles for controlled drug delivery: A review. Mater. Sci. Eng. C 2019, 96, 915–940. [Google Scholar] [CrossRef]
- Bernardes, B.G.; Del Gaudio, P.; Alves, P.; Costa, R.; García-Gonzaléz, C.A.; Oliveira, A.L. Bioaerogels: Promising nanostructured materials in fluid management, healing and regeneration of wounds. Molecules 2021, 26, 3834. [Google Scholar] [CrossRef]
- García-González, C.A.; Budtova, T.; Durães, L.; Erkey, C.; Del Gaudio, P.; Gurikov, P.; Koebel, M.; Liebner, F.; Neagu, M.; Smirnova, I. An opinion paper on aerogels for biomedical and environmental applications. Molecules 2019, 24, 1815. [Google Scholar] [CrossRef] [Green Version]
- García-González, C.A.; Sosnik, A.; Kalmár, J.; De Marco, I.; Erkey, C.; Concheiro, A.; Alvarez-Lorenzo, C. Aerogels in drug delivery: From design to application. J. Control. Release 2021, 332, 40–63. [Google Scholar] [CrossRef]
- López-Iglesias, C.; Barros, J.; Ardao, I.; Monteiro, F.J.; Alvarez-Lorenzo, C.; Gómez-Amoza, J.L.; García-González, C.A. Vancomycin-loaded chitosan aerogel particles for chronic wound applications. Carbohydr. Polym. 2019, 204, 223–231. [Google Scholar] [CrossRef]
- López-Iglesias, C.; Barros, J.; Ardao, I.; Gurikov, P.; Monteiro, F.J.; Smirnova, I.; Alvarez-Lorenzo, C.; García-González, C.A. Jet cutting technique for the production of chitosan aerogel microparticles loaded with vancomycin. Polymers 2020, 12, 273. [Google Scholar] [CrossRef] [PubMed] [Green Version]
- De Cicco, F.; Russo, P.; Reverchon, E.; García-González, C.A.; Aquino, R.P.; Del Gaudio, P. Prilling and supercritical drying: A successful duo to produce core-shell polysaccharide aerogel beads for wound healing. Carbohydr. Polym. 2016, 147, 482–489. [Google Scholar] [CrossRef] [PubMed]
- Raman, S.P.; Keil, C.; Dieringer, P.; Hübner, C.; Bueno, A.; Gurikov, P.; Nissen, J.; Holtkamp, M.; Karst, U.; Haase, H.; et al. Alginate aerogels carrying calcium, zinc and silver cations for wound care: Fabrication and metal detection. J. Supercrit. Fluids 2019, 153, 104545. [Google Scholar] [CrossRef]
- Lovskaya, D.; Menshutina, N.; Mochalova, M.; Nosov, A. Chitosan-based aerogel particles as highly effective local hemostatic agents production process and in vivo evaluations. Polymers 2020, 12, 2055. [Google Scholar] [CrossRef] [PubMed]
- Delivery, A.; Yahya, E.B.; Jummaat, F.; Amirul, A.A.; Adnan, A.S.; Olaiya, N.G.; Abdullah, C.K.; Rizal, S.; Mohamad Haafiz, M.K.; Khalil, H.P.S. A review on revolutionary natural biopolymer-based aerogels for antibacterial delivery. Antibiotics 2020, 9, 648. [Google Scholar]
- Rial-Hermida, M.I.; Rey-Rico, A.; Blanco-Fernandez, B.; Carballo-Pedrares, N.; Byrne, E.M.; Mano, J.F. Recent progress on polysaccharide-based hydrogels for controlled delivery of therapeutic biomolecules. ACS Biomater. Sci. Eng. 2021, 7, 4102–4127. [Google Scholar] [CrossRef] [PubMed]
- Ferreira-Gonçalves, T.; Constantin, C.; Neagu, M.; Reis, C.P.; Sabri, F.; Simón-Vázquez, R. Safety and efficacy assessment of aerogels for biomedical applications. Biomed. Pharmacother. 2021, 144, 112356. [Google Scholar] [CrossRef] [PubMed]
- Jose, J.; Pai, A.R.; Gopakumar, D.A.; Dalvi, Y.; Rubi, V.; Bhat, S.G.; Pasquini, D.; Kalarikkal, N.; Thomas, S. Novel 3D porous aerogels engineered at nano scale from cellulose nano fibers and curcumin: An effective treatment for chronic wounds. Carbohydr. Polym. 2022, 287, 119338. [Google Scholar] [CrossRef]
- Zheng, L.; Zhang, S.; Ying, Z.; Liu, J.; Zhou, Y.; Chen, F. Engineering of aerogel-based biomaterials for biomedical applications. Int. J. Nanomed. 2020, 15, 2363–2378. [Google Scholar] [CrossRef] [Green Version]
- Zhao, S.; Malfait, W.J.; Guerrero-Alburquerque, N.; Koebel, M.M.; Nyström, G. Biopolymer aerogels and foams: Chemistry, properties, and applications. Angew. Chem. Int. Ed. 2018, 57, 7580–7608. [Google Scholar] [CrossRef]
- Puscaselu, R.G.; Lobiuc, A.; Dimian, M.; Covasa, M. Alginate: From food industry to biomedical applications and management of metabolic disorders. Polymers 2020, 12, 2417. [Google Scholar] [CrossRef]
- Ahmed, A.; Getti, G.; Boateng, J. Ciprofloxacin-loaded calcium alginate wafers prepared by freeze-drying technique for potential healing of chronic diabetic foot ulcers. Drug Deliv. Transl. Res. 2018, 8, 1751–1768. [Google Scholar] [CrossRef] [PubMed]
- Ganesan, K.; Budtova, T.; Ratke, L.; Gurikov, P.; Baudron, V.; Preibisch, I.; Niemeyer, P.; Smirnova, I.; Milow, B. Review on the production of polysaccharide aerogel particles. Materials 2018, 11, 2417. [Google Scholar] [CrossRef] [PubMed] [Green Version]
- Yanniotis, S. Mass transfer by diffusion. In Food Engineering Series; Springer: New York, NY, USA, 2008; Volume I, pp. 141–153. [Google Scholar]
- Mo, W.; Kong, F.; Chen, K.; Li, B. Relationship between freeze-drying and supercritical drying of cellulosic fibers with different moisture contents based on pore and crystallinity measurements. Wood Sci. Technol. 2022, 56, 867–882. [Google Scholar] [CrossRef]
- Baudron, V.; Gurikov, P.; Smirnova, I.; Whitehouse, S. Porous starch materials via supercritical-and freeze-drying. Gels 2019, 5, 12. [Google Scholar] [CrossRef] [Green Version]
- Li, X.; Liu, B.; Pei, B.; Chen, J.; Zhou, D.; Peng, J.; Zhang, X.; Jia, W.; Xu, T. Inkjet bioprinting of biomaterials. Chem. Rev. 2020, 120, 10793–10833. [Google Scholar] [CrossRef]
- Feng, J.; Su, B.L.; Xia, H.; Zhao, S.; Gao, C.; Wang, L.; Ogbeide, O.; Feng, J.; Hasan, T. Printed aerogels: Chemistry, processing, and applications. Chem. Soc. Rev. 2021, 50, 3842–3888. [Google Scholar] [CrossRef]
- López-Iglesias, C.; Casielles, A.M.; Altay, A.; Bettini, R.; Alvarez-Lorenzo, C.; García-González, C.A. From the printer to the lungs: Inkjet-printed aerogel particles for pulmonary delivery. Chem. Eng. J. 2019, 357, 559–566. [Google Scholar] [CrossRef]
- Karakaya, E.; Bider, F.; Frank, A.; Teßmar, J.; Schöbel, L.; Forster, L.; Schrüfer, S.; Schmidt, H.-W.; Schubert, D.W.; Blaeser, A.; et al. Targeted printing of cells: Evaluation of ADA-PEG bioinks for drop on demand approaches. Gels 2022, 8, 206. [Google Scholar] [CrossRef]
- Costa, A.M.S.; Alatorre-Meda, M.; Alvarez-Lorenzo, C.; Mano, J.F. Superhydrophobic surfaces as a tool for the fabrication of hierarchical spherical polymeric carriers. Small 2015, 11, 3648–3652. [Google Scholar] [CrossRef]
- Rial-Hermida, M.I.; Oliveira, N.M.; Concheiro, A.; Alvarez-Lorenzo, C.; Mano, J.F. Bioinspired superamphiphobic surfaces as a tool for polymer- and solvent-independent preparation of drug-loaded spherical particles. Acta Biomater. 2014, 10, 4314–4322. [Google Scholar] [CrossRef] [PubMed]
- Alcalá-Cerra, G.; Paternina-Caicedo, A.J.; Moscote-Salazar, L.R.; Gutiérrez-Paternina, J.J.; Niño-Hernández, L.M. Aplicación de vancomicina en polvo dentro de la herida quirúrgica durante cirugías de columna: Revisión sistemática y metaanálisis. Rev. Esp. Cir. Ortop. Traumatol. 2014, 58, 182–191. [Google Scholar] [CrossRef] [PubMed]
- Lipsky, B.A.; Hoey, C. Topical antimicrobial therapy for treating chronic wounds. Clin. Infect. Dis. 2009, 49, 1541–1549. [Google Scholar] [CrossRef] [Green Version]
- Martinez, L.R.; Han, G.; Chacko, M.; Mihu, M.R.; Jacobson, M.; Gialanella, P.; Friedman, A.J.; Nosanchuk, J.D.; Friedman, J.M. Antimicrobial and healing efficacy of sustained release nitric oxide nanoparticles against staphylococcus aureus skin infection. J. Investig. Dermatol. 2009, 129, 2463–2469. [Google Scholar] [CrossRef] [Green Version]
- Gurikov, P.; Smirnova, I. Non-conventional methods for gelation of alginate. Gels 2018, 4, 14. [Google Scholar] [CrossRef] [PubMed] [Green Version]
- Yarin, A.L. Drop impact dynamics: Splashing, spreading, receding, bouncing. Annu. Rev. Fluid Mech. 2006, 38, 159–192. [Google Scholar] [CrossRef]
- Xu, Q.; Basaran, O.A. Computational analysis of drop-on-demand drop formation. Phys. Fluids 2007, 19, 102111. [Google Scholar] [CrossRef]
- Rodríguez-Dorado, R.; López-Iglesias, C.; García-González, C.A.; Auriemma, G.; Aquino, R.P.; Del Gaudio, P. Design of aerogels, cryogels and xerogels of alginate: Effect of molecular weight, gelation conditions and drying method on particles’ micromeritics. Molecules 2019, 24, 1049. [Google Scholar] [CrossRef] [Green Version]
- Gonçalves, V.S.S.; Gurikov, P.; Poejo, J.; Matias, A.A.; Heinrich, S.; Duarte, C.M.M.; Smirnova, I. Alginate-based hybrid aerogel microparticles for mucosal drug delivery. Eur. J. Pharm. Biopharm. 2016, 107, 160–170. [Google Scholar] [CrossRef]
- Fang, B.; Qiu, P.; Xia, C.; Cai, D.; Zhao, C.; Chen, Y.; Wang, H.; Liu, S.; Cheng, H.; Tang, Z.; et al. Extracellular matrix scaffold crosslinked with vancomycin for multifunctional antibacterial bone infection therapy. Biomaterials 2021, 268, 120603. [Google Scholar] [CrossRef]
- Sing, K.S.; Everett, D.H.; Haul, R.A.W.; Moscou, L.; Pierotti, R.A.; Rouquerol, J. IUPAC recommendations reporting physisorption data for gas/solid systems. Appl. Catal. 1988, 37, 515–531. [Google Scholar]
- Robitzer, M.; Tourrette, A.; Horga, R.; Valentin, R.; Boissire, M.; Devoisselle, J.M.; Di Renzo, F.; Quignard, F. Nitrogen sorption as a tool for the characterisation of polysaccharide aerogels. Carbohydr. Polym. 2011, 85, 44–53. [Google Scholar] [CrossRef]
- Ritger, P.L.; Peppas, N.A. A simple equation for description of solute release II. Fickian and anomalous release from swellable devices. J. Control. Release 1987, 5, 37–42. [Google Scholar] [CrossRef]
- Wang, C.; Okubayashi, S. 3D aerogel of cellulose triacetate with supercritical antisolvent process for drug delivery. J. Supercrit. Fluids 2019, 148, 33–41. [Google Scholar] [CrossRef]
- Marin, M.A.; Mallepally, R.R.; McHugh, M.A. Silk fibroin aerogels for drug delivery applications. J. Supercrit. Fluids 2014, 91, 84–89. [Google Scholar] [CrossRef]
- Antunes, J.; Gaspar, V.M.; Ferreira, L.; Monteiro, M.; Henrique, R.; Jerónimo, C.; Mano, J.F. In-air production of 3D co-culture tumor spheroid hydrogels for expedited drug screening. Acta Biomater. 2019, 94, 392–409. [Google Scholar] [CrossRef]
- Lovskaya, D.D.; Lebedev, A.E.; Menshutina, N.V. Aerogels as drug delivery systems: In vitro and in vivo evaluations. J. Supercrit. Fluids 2015, 106, 115–121. [Google Scholar] [CrossRef]
- Ghasemiyeh, P.; Vazin, A.; Zand, F.; Azadi, A.; Karimzadeh, I.; Mohammadi-Samani, S. A simple and validated HPLC method for vancomycin assay in plasma samples: The necessity of TDM center development in Southern Iran. Res. Pharm. Sci. 2020, 15, 529–540. [Google Scholar] [CrossRef]
- De Jesús Valle, M.J.; López, F.G.; Navarro, A.S. Development and validation of an HPLC method for vancomycin and its application to a pharmacokinetic study. J. Pharm. Biomed. Anal. 2008, 48, 835–839. [Google Scholar] [CrossRef]
- García-González, C.A.; Jin, M.; Gerth, J.; Alvarez-Lorenzo, C.; Smirnova, I. Polysaccharide-based aerogel microspheres for oral drug delivery. Carbohydr. Polym. 2015, 117, 797–806. [Google Scholar] [CrossRef] [Green Version]

| Type I | Type II | Type III | |
|---|---|---|---|
| Vancomycin loading (µg/mg particles) | 26.59 (±0.17) | 17.22 (±0.35) | 33.01 (±0.47) |
| Entrapment yield (%) | 15.63 (±0.10) | 10.13 (±0.20) | 19.41 (±0.28) |
| Formulations | aBET (m2/g) * | VP,BJH (cm3/g) ** | DP,BJH (nm) *** |
|---|---|---|---|
| Blank aerogels | 312 (16) | 0.80 (0.04) | 11.2 (0.6) |
| Type I | 742 (37) | 3.90 (0.20) | 21.8 (1.1) |
| Type II | 268 (13) | 2.54 (0.13) | 35.2 (1.8) |
| Type III | 530 (26) | 2.65 (0.13) | 21.0 (1.0) |
| Kinetic Model | Parameters | Type I | Type II | Type III |
|---|---|---|---|---|
| Ritger-Peppas | k (h−1) | 8.24 | 13.88 | 3.35 |
| n | 0.48 | 0.39 | 0.41 | |
| R2 | 0.96 | 0.94 | 0.96 | |
| Higuchi | k (h−1/2) | 0.38 | 11.18 | 8.85 |
| n | 8.13 | 8.91 | 6.82 | |
| R2 | 0.95 | 0.93 | 0.97 | |
| Zero order | k (h−1) | 13.42 | 6.30 | 22.93 |
| n | 0.914 | 0.87 | 0.64 | |
| R2 | 0.87 | 0.96 | 0.92 | |
| First order | k (h−1) | 87.35 | 100.48 | 79.04 |
| n | 0.011 | 0.016 | 0.012 | |
| R2 | 0.93 | 0.93 | 0.97 |
Publisher’s Note: MDPI stays neutral with regard to jurisdictional claims in published maps and institutional affiliations. |
© 2022 by the authors. Licensee MDPI, Basel, Switzerland. This article is an open access article distributed under the terms and conditions of the Creative Commons Attribution (CC BY) license (https://creativecommons.org/licenses/by/4.0/).
Share and Cite
Remuiñán-Pose, P.; López-Iglesias, C.; Iglesias-Mejuto, A.; Mano, J.F.; García-González, C.A.; Rial-Hermida, M.I. Preparation of Vancomycin-Loaded Aerogels Implementing Inkjet Printing and Superhydrophobic Surfaces. Gels 2022, 8, 417. https://doi.org/10.3390/gels8070417
Remuiñán-Pose P, López-Iglesias C, Iglesias-Mejuto A, Mano JF, García-González CA, Rial-Hermida MI. Preparation of Vancomycin-Loaded Aerogels Implementing Inkjet Printing and Superhydrophobic Surfaces. Gels. 2022; 8(7):417. https://doi.org/10.3390/gels8070417
Chicago/Turabian StyleRemuiñán-Pose, Patricia, Clara López-Iglesias, Ana Iglesias-Mejuto, Joao F. Mano, Carlos A. García-González, and M. Isabel Rial-Hermida. 2022. "Preparation of Vancomycin-Loaded Aerogels Implementing Inkjet Printing and Superhydrophobic Surfaces" Gels 8, no. 7: 417. https://doi.org/10.3390/gels8070417







